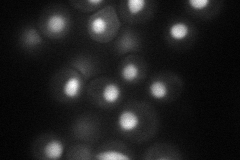
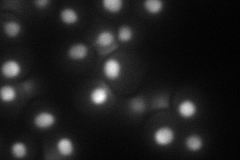
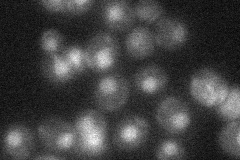
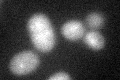
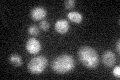

View description
Pre-mRNA splicing factor, facilitates the cooperative formation of U2/U6 helix II in association with stem II in the spliceosome, function may be regulated by Slu7p
Localization:
Intensity:
Fold change:
Significance:
-
C’ GFP library in SD

below threshold16.5 -
N' NOP1pr-GFP in SD
nucleus62.2376 -
N' TEF2pr-mCherry in SD
nucleus66.1356 -
N' NATIVEpr-GFP in SD
nucleus28.9197 -
N' TEF2pr-VC and Cyto-VN in SD

#N/A0 -
C’ GFP library in SD+DTT
cytosol15.390.93No -
C’ GFP library in SD+H2O2

cytosol18.811.14No -
C’ GFP library in Starvation Media
cytosol25.951.57No -
C’ GFP library on the background of Pup2-DaMP

below threshold -
C’ GFP library on the background of CCT mutant

below threshold16.10210.97573No
